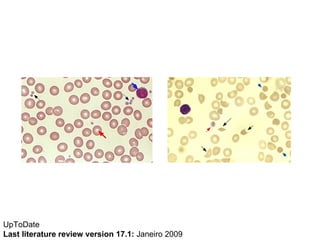
UpToDate  Last literature review version 17.1:  Janeiro 2009
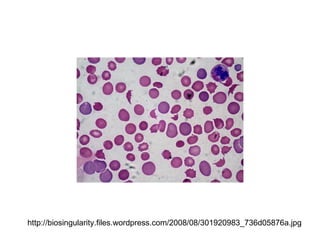
http://biosingularity.files.wordpress.com/2008/08/301920983_736d05876a.jpg

O caso clínico descreve uma paciente de 66 anos com anemia e insuficiência grave de válvula aórtica, requerendo cirurgia cardíaca. Exames revelam plaquetopenia e hemólise mecânica, com complicações pós-operatórias como sangramento profuso. As discussões incluem causas da anemia, plaquetopenia e implicações da coagulação, sugerindo a necessidade de monitoramento rigoroso e tratamento adequado.